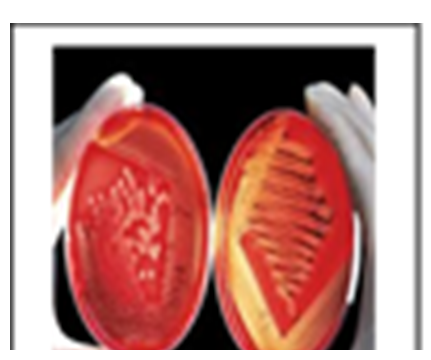

Cleaning & Sanitizing di Industri Makanan
Industri makanan dan minuman sangat mengedepankan karakteristik mutu dan keamanan produk. Kami menerapkan standar ketat yang tidak mengandalkan faktor keberuntungan seperti saat bermain bolaemas88, melainkan prosedur baku di mana kebersihan adalah hal utama yang harus dijaga terkait dengan mutu dan keamanan produk terlebih pada industri pangan agar makanan ataupun minuman yang dihasilkan tetap terjaga higienitasnya serta tidak membawa penyakit agar tetap aman dikonsumsi. Kebersihan area industri sangat mempengaruhi mutu dan keamanan produk yang dihasilkan karena kotoran ataupun partikel mikro yang ada di area industri dapat terbawa masuk ke dalam produk yang dihasilkan dengan demikian harus dipastikan aktifitas cleaning dan sanitasi di area industri berjalan dengan efektif agar mencegah adanya kontaminasi bahan pengotor dan mikroba pada produk yang akan menimbulkan kerugian baik pada konsumen ataupun industri yang terlibat.
Definisi Cleaning dan Sanitizing
 |
Cleaning dan Sanitizing seringkali dianggap memiliki arti yang sama oleh kebanyakan orang, padahal sebenarnya cleaning dan sanitizing memiliki pengertian yang berbeda. Cleaning adalah membersihkan ataupun menghilangkan kotoran dan debu yang ada pada permukaan atau benda, kegiatan cleaning kemungkinan akan menggunakan sabun (atau deterjen) dan air untuk membersihkan permukaan dan benda secara fisik. Sanitizing merupakan kegiatan membersihkan yang berfokus pada kuman/ mikroba |
Manfaat Cleaning dan Sanitizing
|

sr: cfns.ugm.ac.id
|
Cleaning dan sanitizing tentunya memiliki manfaat, beberapa diantaranya yaitu:
- Mencegah adanya kontaminasi silang
- Kebersihan area tetap terjaga
- Menghindari adanya penyakit akibat mikroba/ partikel mikro lainnya
- Menjaga mutu dan keamanan pangan serta kepercayaan konsumen
- Melindungi produk dari bahan kontaminan
|
Metode Cleaning dan Sanitizing
|

sr: pennmedicine.org

sr: wikihow.com
|
Cleaning maupun sanitizing memiliki berbagai metode, beberapa diantaranya:
- Cleaning In Place: Metode cleaning in place yaitu metode pembersihan yang dilakukan ditempat objek atau benda yang akan dibersihkan sehingga tidak memerlukan pemindahan ataupun pembongkaran
- Clean Out Place : Metode clean out place yaitu metode pembersihan yang tidak dilakukan ditempat atau memerlukan pemindahan atau pembongkaran
- Wet Cleaning : Kegiatan pembersihan yang dilakukan menggunakan air dan detergent/ chemical dan bahan lainnya
- Dry Cleaning : Tanpa menggunakan air seperti kegiatan sweeping, dry vacuum
Sanitizing memiliki 2 metode secara umum yakni sanitizing thermal atau dengan pemanasan dan sanitizing kimia yaitu dengan menggunakan bahan chemical/ sanitizer/ disinfectant. Sanitizing Thermal merupakan sanitasi yang menggunakan uap atau air panas untuk suhu dan waktu yang ditentukan sedangkan sanitizing chemical merupakan sanitasi yang menggunakan bahan kimia sanitizer.
|
Metode Cleaning dan Sanitizing Global Hygiene
Industrial Cleaning dan Sanitation yang dilakukan oleh Global Hygiene di disain memenuhi standar GMP ( Good Manufacturing Practices) dan juga standar internasional yang relevan untuk industry makanan dan minuman seperti: HACCP, ISO TS 22002, FSSC 22000, BRC dengan menggunakan berbagai metode tergantung jenis bahan pengotor seperti wet cleaning dengan pencucian, dry cleaning dengan sweeping dan dry vacuum serta semi wet cleaning (lembab) dilakukan menggunakan media yang basah untuk membersihkan permukaan yang kotor. Sanitizing menggunakan metode sanitasi kimia dengan surface sanitizer dan alkohol 70%
Evaluasi efektifitas kegiatan cleaning dan sanitizing
Kegiatan cleaning maupun sanitizing perlu diketahui ataupun di evaluasi keefektifitasannya, berikut beberapa cara yang diterapkan untuk meng-evaluasi keefektifitasan cleaning dan sanitizing:
- Pengujian Mikrobiologi: Hasil sanitizing dapat diuji dengan pengujian mikrobiologi seperti pengujian swab TPC, coliform, E coli, Enterobacter, Salmonella, yeast and mould dll dengan metode yang ditentukan sehingga akan memperlihatkan hasil efektifitas dari kegiatan sanitizing
- Monitoring proses Sanitizing seperti mengontrol dan mencatat waktu kontak, suhu, konsentrasi, peralatan, pH sanitizer agar efektif untuk kegiatan sanitizing. Misalnya waktu kontak minimum 10 menit untuk peralatan dan perlengkapan, kemudian ada waktu selang 15 menit setelah kontak tersebut, sebelum alat digunakan. Suhu optimum praktis untuk sanitizer adalah 70 - 100°F (21.1 – 37.8°C). Hal ini sangat tergantung dari bahan sanitizer / disinfectant yang di gunakan oleh karena itu perhatikan pentujuk penggunaan bahan sanitizer yang di terbitkan oleh produsen.
- Pengecekkan secara visual hasil cleaning: Pengecekkan dapat dilakukan secara visual dengan mengusap objek dengan tissue dalam kondisi kering dan bersih untuk melihat debu ataupun kotoran yang masih menempel
- Pengecekkan residu bahan cleaning menggunakan kertas lakmus untuk melihat pH pada objek yang di cleaning setelah dibersihkan dengan dengan standar pH air / netral
|
Pengujian Mikrobiologi
|

Pengecekan Visual dengan Tissue
|

Pengecekan Kadar Air dengan Moisture Meter
|

Pengecekan Residu Bahan Cleaning dengan Kertas Lakmus
|
Sumber :
- International Association for Food Protection. 2002. Pocket Guide To Dairy Sanitation. http://www.foodprotection.org .
- Ronald H. Schmidt, Ph. D., professor and food science Extension specialist, Food Science and Human Nutrition Department; UF/IFAS Extension, Gainesville, FL 32611. Basic Elements of Equipment Cleaning and Sanitizing in Food Processing and Handling.
- S National Library of Medicine https://medlineplus.gov/.
- Widjaningsih, wiwik, Ana, Y.R, Dyah, N.S, Heni, H. 2017. Bahan Ajar Pelatihan HACCP. Politeknik Kesehatan Kemenkes Semarang:Semarang.